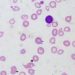
Nonlinear relationship between maternal hemoglobin and infant development

1. Discrepancies between follow-up imaging infarct volume and functional outcomes were associated with differences in baseline characteristics and post-stroke complications among acute ischemic stroke patients with large vessel occlusions who received endovascular thrombectomy.
2. Control of post-stroke complications, such as blood pressure, glucose, and hemoglobin levels, may improve long-term functional outcomes among acute ischemic stroke patients.
Evidence Rating Level: 2 (Good)
Study Rundown: Acute ischemic strokes can lead to poor functional outcomes. Follow-up imaging infarct volume (FIV) is measured 24-48 hours after a stroke and is associated with functional outcomes at 90 days. The modified Rankin Scale (mRS) is used to assess outcomes in patients with large-vessel occlusion strokes. However, recent evidence demonstrated that FIV was not a great predictor of mRS score as FIV was only modestly correlated with long-term outcomes. The ESCAPE trial showed that 1/8 patients had discrepancies between FIV and mRS at 90 days post-stroke. This cohort study, a post-hoc analysis of the ESCAPE-NA1 randomized controlled trial, investigated the factors leading to the discrepancies between FIV and functional outcomes among patients who received endovascular thrombectomy for ischemic stroke management. Among patients with a small FIV (<25th percentile), those with mRS score >3 were classified as discrepant and those with mRS score 0-2 were non-discrepant. Among patients with a large FIV (>75th percentile), those with mRS score 0-2 were classified as discrepant and patients with mRS score >3 were non-discrepant. First, small FIV (<25th percentile) patients were examined. The discrepant group was more likely to be older, have pre-existing cancer, have more vascular risk factors, and be less likely to have a pre-stroke mRS score of 0. Furthermore, discrepant cases demonstrated lower hemoglobin and hematocrit values at 24 hours post-stroke, higher 24- and 48-hour post-stroke National Institutes of Health Stroke Score (NIHSS), and more serious adverse events (SAEs). Next, large FIV patients (>75th percentile) were assessed. The discrepant group was more likely to be younger, have lower systolic blood pressure (SBP), be less likely to have pre-existing diabetes, and have higher hemoglobin. Additionally, they had lower 24- and 48-hour post-stroke NIHSS, lower SBP, lower glucose, higher hemoglobin, and fewer SAEs among treatment-related and post-treatment variables. Overall, the discrepancies found between FIV and functional outcomes were related to differences in baseline characteristics, such as age and co-morbidities, and post-stroke complications. It is important to consider that scanner (MRI vs CT) and protocol differences at the various sites may have affected the FIV calculations.
Click to read the study in JAMA Network Open
Relevant Reading: Intra-arterial therapy and post-treatment infarct volumes: Insights from the ESCAPE randomized controlled trial
In-Depth [retrospective cohort]: This study was a post-hoc analysis of the ESCAPE-NA1 double-blind, randomized, placebo-controlled clinical trial that included 48 hospitals from 8 countries. Patients were eligible if they suffered from an acute ischemic stroke due to a large vessel occlusion within 12 hours from the last known time of being well. Patients were enrolled from March 1, 2017, until August 12, 2019, and follow-up was 90-days post-stroke. Functional outcomes were assessed with the mRS score. A mRS score of 0-2 is classified as a good outcome and a mRS score of >3 is classified as a poor outcome. Among 1091 patients with FIV and 90-day mRS scores, 287 were in the <25th percentile and 275 were in the >75th percentile. Discrepant groups were those with an mRS score >3 in the <25th percentile cohort (small FIV but high mRS) and patients with an mRS score 0-2 in the >75th percentile cohort (large FIV but low mRS). This study utilized two models for analysis: a) the model with prespecified variables based on the ESCAPE trial analysis, and b) a model with variables selected by multivariable logistic regression. The outcomes of this study were whether the models could assess whether prespecified factors can identify patients with small FIV and high mRS and large FIV with low mRS. Baseline characteristics, outcomes, treatments, and serious adverse events (infarct in new territory [INT], recurrent stroke, pneumonia, CHF) were compared between discrepant and non-discrepant groups. Upon assessment of the discrepant group in small FIV patients, pre-treatment factors, such as age (adjusted odds ratio [aOR]: 1.08 [95% CI: 1.04-1.13]), cancer (aOR: 61.65 [95% CI: 2.91-1304.27]), and vascular risk factors (aOR: 1.30 [95% CI: 1.06-1.59]), and post-treatment factors, such as SAE (aOR: 3.46 [95% CI: 1.72-6.96]) and hemoglobin level at 24 hours (aOR: 0.97 [95% CI: 0.91-0.96]) were significantly different compared to the non-discrepant group. Upon assessment of the discrepant group in large FIV patients, pre-treatment characteristics, including age (aOR: 0.97 [95% CI: 0.95-0.99]) and pre-existing diabetes (aOR: 0.38 [95% CI: 0.16-0.92]), and post-treatment factors, such as SAE (aOR: 0.13 [95% CI: 0.05-0.30]), stroke progression (aOR: 0.05 [95% CI: 0.01-0.25]), and hemoglobin level at 24 hours (aOR: 1.02 [95% CI: 1.01-1.04]) were significantly different compared to the non-discrepant group.
Image: PD
©2021 2 Minute Medicine, Inc. All rights reserved. No works may be reproduced without expressed written consent from 2 Minute Medicine, Inc. Inquire about licensing here. No article should be construed as medical advice and is not intended as such by the authors or by 2 Minute Medicine, Inc.